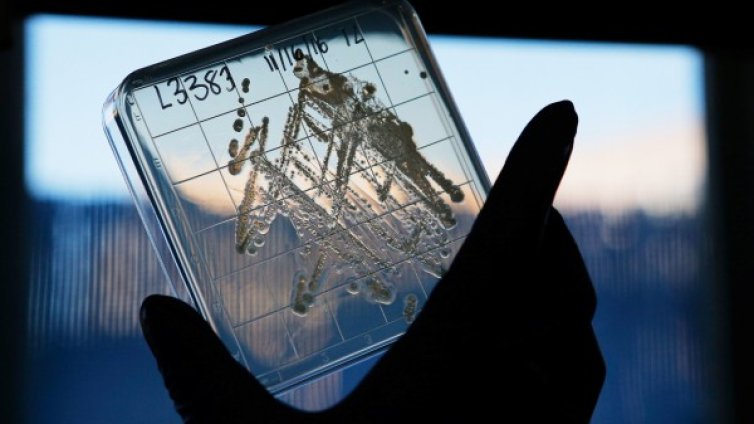
Антибиотична резистентност - какви рискове крие?

Новини
-
Светът на ръба: Украйна, Близкият изток и кризата на дипломацията
-
Украинци: Не ни съдете, че вземаме руски паспорти - искаме да оцелеем
-
Две цигански фамилии се биха с мотики в Берковица, има пострадали
-
Естония: Украйна да продължи да нанася удари по военна инфраструктура в руския тил
-
Има и добро: Полицията ескортира кола с аварийни до болница, не глоби шофьора
-
Племенникът на Ел Чапо е арестуван в Мексико
-
Христо Мутафчиев: По-важно е да има повече пари за театъра
-
Руското посолство у нас: Днес почитаме създателите на първата славянска азбука
-
Старо интервю на Слави Трифонов с Дара предизвика възмущение онлайн ВИДЕО
-
Тежко престъпление е по-вероятната версия за трагедията в Благоевград?
-
Демерджиев обяви чистка в МВР и безкомпромисна борба с нарушенията в системата
-
Украйна използва цивилни, майки и таксиметрови шофьори, за да свалят руски дронове
-
Никола Цолов: Предателство е единствената правилна дума за чувствата ми в момента
-
Трагедия в Белгия: Влак блъсна училищен автобус, има жертви ВИДЕО
-
Философията на Дугин: Руснаците не са войнствен народ, живеят мирно в окопите
-
Тук не е за бедни: Пицата в София е 13 евро, колкото в Люксембург
-
Станаха лукс: Българите масово купуват по 100–300 грама череши, само за опитване ВИДЕО
-
Руското посолство у нас: Днес почитаме създателите на първата славянска азбука
-
Лавров уведомил САЩ: Русия започва последователни удари по обекти в Киев
-
Тайният руски проект "Скити": ядрени ракети на морското дъно
-
Мицкоски твърд: РСМ няма да прави конституционни промени, ще си платим цената

Войната в Иран подкрепя железопътния план на Казахстан за свързване на ЕС и Китай
Войната в Иран подкрепя железопътния план на Казахстан за свързване на ЕС и Китай  SOFIX се понижи при оборот от близо 34 млн. евро
SOFIX се понижи при оборот от близо 34 млн. евро  Нова анкета показва, че Жордан Бардела ще спечели президентските избори във Франция
Нова анкета показва, че Жордан Бардела ще спечели президентските избори във Франция  Сам Алтман: AI едва ли ще доведе до апокалипсис на работните места
Сам Алтман: AI едва ли ще доведе до апокалипсис на работните места  Петър Атанасов: Инфлацията у нас е близо 7%, но усещането е за много по-висок ръст
Петър Атанасов: Инфлацията у нас е близо 7%, но усещането е за много по-висок ръст  Защо антените на руските дипломатически сгради притесняват Европа?
Защо антените на руските дипломатически сгради притесняват Европа? 
 Водоемите след валежите: 32 големи язовира у нас са пълни над 80%
Водоемите след валежите: 32 големи язовира у нас са пълни над 80%  Никола Стоянов: Обществото ще плати цената за безкрайните въртележки в управлението
Никола Стоянов: Обществото ще плати цената за безкрайните въртележки в управлението  Движение срещу болката: Как функционалните тренировки спасяват гърба и кръста
Движение срещу болката: Как функционалните тренировки спасяват гърба и кръста  Централна емисия
Централна емисия  Крум Зарков: С реформите има риск КЗП и КЗК да бъдат наричани "бухалки"
Крум Зарков: С реформите има риск КЗП и КЗК да бъдат наричани "бухалки"  Централна емисия
Централна емисия 
 „Червена“ България е в еуфория + ВИДЕО
„Червена“ България е в еуфория + ВИДЕО  Треньорът на Райо призна: Все още се носим в облаците след постигнатото до момента
Треньорът на Райо призна: Все още се носим в облаците след постигнатото до момента  Голяма и отлична новина за Гришо
Голяма и отлична новина за Гришо  Гонзо избесня: БФС спря правата на скандалните съдии подпряли нагло Лудогорец
Гонзо избесня: БФС спря правата на скандалните съдии подпряли нагло Лудогорец  Светльо Вуцов изригна с коментар за младок
Светльо Вуцов изригна с коментар за младок  Бивш съдия изригна за безобразията срещу ЦСКА в Разград
Бивш съдия изригна за безобразията срещу ЦСКА в Разград 
 Лесен канелен кекс с ябълки и орехи
Лесен канелен кекс с ябълки и орехи  „България Еър“ предлага през лятото четири полета дневно до Варна и обратно
„България Еър“ предлага през лятото четири полета дневно до Варна и обратно  Задължителни подавки за Черешова задушница
Задължителни подавки за Черешова задушница  „Протокол Хаос“ от Жозе Родригеш душ Сантуш
„Протокол Хаос“ от Жозе Родригеш душ Сантуш  Хитовият турски сериал „В името на сина ми“ тръгва от 8 юни
Хитовият турски сериал „В името на сина ми“ тръгва от 8 юни  Как четенето променя начина, по който виждате света
Как четенето променя начина, по който виждате света 
 продава, Двустаен апартамент, 43 m2 Бургас област, к.к.Слънчев Бряг, 53999.83 EUR
продава, Двустаен апартамент, 43 m2 Бургас област, к.к.Слънчев Бряг, 53999.83 EUR  продава, Четиристаен апартамент, 87 m2 София, Дружба 1, 215000 EUR
продава, Четиристаен апартамент, 87 m2 София, Дружба 1, 215000 EUR  продава, Тристаен апартамент, 87 m2 София, Дружба 1, 215000 EUR
продава, Тристаен апартамент, 87 m2 София, Дружба 1, 215000 EUR  продава, Едностаен апартамент, 34 m2 Бургас област, к.к.Слънчев Бряг, 45000 EUR
продава, Едностаен апартамент, 34 m2 Бургас област, к.к.Слънчев Бряг, 45000 EUR  продава, Едностаен апартамент, 20 m2 Бургас област, к.к.Слънчев Бряг, 33000 EUR
продава, Едностаен апартамент, 20 m2 Бургас област, к.к.Слънчев Бряг, 33000 EUR  продава, Тристаен апартамент, 74 m2 Пловдив, Кючук Париж, 147000 EUR
продава, Тристаен апартамент, 74 m2 Пловдив, Кючук Париж, 147000 EUR 
 Путин е измислил нов начин за привличане на хора в армията
Путин е измислил нов начин за привличане на хора в армията  Симеон Дянков: За да имаш добро изпълнение на фискалната политика, трябва да имаш играчи
Симеон Дянков: За да имаш добро изпълнение на фискалната политика, трябва да имаш играчи  Психолог: Възрастовата граница при употреба на наркотици пада
Психолог: Възрастовата граница при употреба на наркотици пада  Ръст на резервациите в Гърция въпреки високите цени
Ръст на резервациите в Гърция въпреки високите цени  Тръмп премина годишен медицински преглед дни преди да навърши 80 години
Тръмп премина годишен медицински преглед дни преди да навърши 80 години  Германският бизнес запазва доверие в България въпреки глобалната несигурност
Германският бизнес запазва доверие в България въпреки глобалната несигурност 
 SpaceX избра криптомилиардер за командир на първата си пилотирана мисия до Марс
SpaceX избра криптомилиардер за командир на първата си пилотирана мисия до Марс  Европа под обсадата на гореща вълна: Рекордни температури и първи жертви
Европа под обсадата на гореща вълна: Рекордни температури и първи жертви  Китайски учени създадоха туптящо сърце в епруветка: Може да замени пейсмейкърите
Китайски учени създадоха туптящо сърце в епруветка: Може да замени пейсмейкърите  Астробиолози предлагат използването на AI в търсенето на извънземен живот
Астробиолози предлагат използването на AI в търсенето на извънземен живот  Гъби могат да превърнат лунната почва в плодородна земя
Гъби могат да превърнат лунната почва в плодородна земя  Как Хеопсовата пирамида устоява на земетресения в продължение на хилядолетия?
Как Хеопсовата пирамида устоява на земетресения в продължение на хилядолетия?